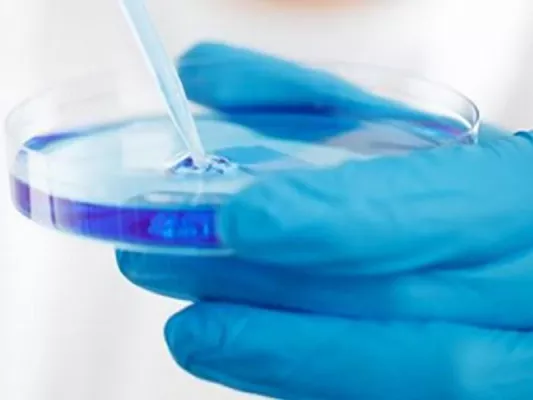
Bild: Expertenreaktionen auf kalifornische Studie: Geringeres Risiko der E-Zigarette erneut bestätigt

(openPR) Obwohl frühere Studien bereits eine Beziehung zwischen Potenzstörung (erektile Dysfunktion) und Rauchen beschrieben haben, wurde der Einfluss von Passivrauchen auf diese Form der Potenzstörung noch nicht hinreichend untersucht. Der Einfluss von aktivem und passivem Rauchen auf die Entstehung einer erektilen Dysfunktion und der Nachweis einer möglichen Abhängigkeit von der Menge des Nikotinkonsums war daher Gegenstand einer aktuellen Studie. Sie ergab, dass der Genuss von einem Päckchen Zigaretten pro Tag über einen Zeitraum von zwanzig Jahren mit großer Wahrscheinlichkeit zu Potenzstörungen führt.
>> Zusätzliche Informationen zu diesem Thema finden Sie im eJournal MEDIZIN ASPEKTE unter der URL
http://medizin-aspekte.de/07/05/medizin/abstracts.html
Weitere Artikel aus der Welt der Gesundheit und Medizin bietet die aktuelle Ausgabe des eMagazins MEDIZIN ASPEKTE, das kostenlos unter www.medizin-aspekte.de zu erreichen ist.
****
Ihr Ansprechpartner:
Dr. J. Wolff
Redaktion MEDIZIN ASPEKTE
Tel.: 06241 - 9 55 421
www.medizin-aspekte.de
![]()
****
Presseinformation
Potenzstörungen: Ursache kann das Rauchen sein
Diese Pressemeldung wurde auf openPR veröffentlicht.
Verantwortlich für diese Pressemeldung:Erfolgskurs des eMagazins MEDIZIN ASPEKTE ist ungebrochen
Das Journal verzeichnet seit Jahren stetigen Leserzuwachs. In 2007 überschritten die Zugriffszahlen erstmalig einen Monatswert von 7,5 Mio. Kontakten. Die Geschäftsführerin des Verlags MCP Wolff, Martina Wolff (43): "Dieser Meilenstein ist zugleich unser bisheriger Höchstwert, der einer Verdoppelung des Vorjahreswerts entspricht. Wir führen den Erfolg vor allem auf die Kontinuität in der Ansprache unserer Leser zurück." Dabei übernimmt die Auswahl der Themen für die Leserschaft aus Patienten und Angehörigen eine Schlüsselfunktion.
Das Journal verzeichnet seit Jahren stetigen Leserzuwachs. In 2007 überschritten die Zugriffszahlen erstmalig einen Monatswert von 7,5 Mio. Kontakten. Die Geschäftsführerin des Verlags MCP Wolff, Martina Wolff (43): "Dieser Meilenstein ist zugleich unser bisheriger Höchstwert, der einer Verdoppelung des Vorjahreswerts entspricht. Wir führen den Erfolg vor allem auf die Kontinuität in der Ansprache unserer Leser zurück." Dabei übernimmt die Auswahl der Themen für die Leserschaft aus Patienten und Angehörigen eine Schlüsselfunktion.
Über das Unternehmen
MEDIZIN ASPEKTE ist ein monatlich erscheinendes eMagazin zu Themen der Gesundheitsvorsorge und Gesundheitspflege, mit aktuellen Infos und praktischen Ratschlägen zu Krankheiten und Gesundheitsbeschwerden. Im 'Webadressbuch für Deutschland 2007' wird der Titel in der Rubrik 'Gesundheit/Zeitungen & Zeitschriften' zu den TOP 5 gezählt. Das eJournal wendet sich an alle Gesundheitsbewußten sowie im geschlossenen Bereich an medizinische Fachkreise. Die Nutzung der aktuellen sowie aller bisher erschienenen Ausgaben mit über 5.500 Artikel unter www.medizin-aspekte.de ist kostenlos.
Pressebericht „Potenzstörungen: Ursache kann das Rauchen sein“ bearbeiten oder mit dem "Super-PR-Sparpaket" stark hervorheben, zielgerichtet an Journalisten & Top50 Online-Portale verbreiten:
Disclaimer: Für den obigen Pressetext inkl. etwaiger Bilder/ Videos ist ausschließlich der im Text angegebene Kontakt verantwortlich. Der Webseitenanbieter distanziert sich ausdrücklich von den Inhalten Dritter und macht sich diese nicht zu eigen. Wenn Sie die obigen Informationen redaktionell nutzen möchten, so wenden Sie sich bitte an den obigen Pressekontakt. Bei einer Veröffentlichung bitten wir um ein Belegexemplar oder Quellenennung der URL.
Weitere Mitteilungen von MEDIZIN ASPEKTE


Top Acts wie Anna Joan - Fred Freytag - Die Fantastischen Vier - Smudo - Joy Denalane begeisterten in Mainz
Mit mehr als 64.000 Zuschauern hat sich das Rheinland-Pfalz Open Air in den letzten Jahren zu einem der größten kostenlosen Events in Rheinland-Pfalz und in gesamt Deutschland etabliert. 10 Stunden lang hieß es „Bühne frei“ für Top Acts aus Deutschland und für international gefragte Größen. Durch das Programm führten mit Witz und Charme Morningshow Moderator Kunze und die Moderatorin Nadja.
Den Auftakt zum Festival gab die Siegerband des Wettbewerbs „Gewinn den Gig“. Anmoderiert von Ernst-Marcus Thomas, dem Moderator des ZDF Fernsehgarten, l…

Sinnestäuschung beim Hören - Der eigenen Wahrnehmung misstrauen
Wer längere Zeit konzentriert auf einen Wasserfall blickt und anschliessend auf eine unbewegte Szene, meint plötzlich, eine Bewegung nach oben wahrzunehmen. Diese "Wasserfall-Täuschung" beschrieb Aristoteles bereits vor über 2000 Jahren in seiner kleinen Naturkunde "Parva Naturalia". Doch erst in jüngerer Vergangenheit lieferten amerikanische Forscher per Experiment eine plausible Erklärung für dieses Phänomen eines Bewegungs-Nacheffektes. Verantwortlich für diese Sinnestäuschung sind unsere Nervenzellen, die Neuronen. Sie arbeiten in Aufgabe…
Das könnte Sie auch interessieren:


Tabakatlas: Möbelpacker sind die stärksten Raucher
… zusätzlich: Fast 56% der Männer und fast 43% der Frauen. Bei den Erwerbstätigen rauchen knapp 34% der Männer und 27% der Frauen. In welchem Umfang Erwerbslosigkeit die Ursache oder die Folge des teils exzessiven Nikotinkonsums ist, lässt sich statistisch kaum klären.
Auch bei den Berufsgruppen ist die Tendenz klar: Je geringer die Qualifikation, desto …

Stoßwellentherapie – schmerzfrei leben durch moderne Schallwellen
Ob Myofasziales Schmerzsyndrom oder Potenzstörungen - die Stoßwellentherapie dringt in immer mehr Bereiche der Medizin vor. Wen wundert´s: Kaum eine Behandlungsmethode ist gleichzeitig so schonend und effektiv. Inzwischen kommen ganz neue Geräte zum Einsatz, die eine flächenhafte Behandlung ermöglichen.
Die Stoßwellentherapie kommt in der Medizin auf …

Expertenreaktionen auf kalifornische Studie: Geringeres Risiko der E-Zigarette erneut bestätigt
… Deutschen Krebsforschungszentrum, Heidelberg in einem Interview mit dem WDR:
"Es gibt keinen klaren Beleg für die Aussage der Studie, dass E-Zigaretten schwere Lungenerkrankungen verursachen. […] Es ist auch möglich, dass das Risiko für Lungenerkrankungen bei E-Zigarettennutzer auf deren früheres Rauchverhalten zurückzuführen ist. […] Laut der Studie ist …

Raucherentwöhnung mit Hypnose
… Gefäßverschlüsse sind oft die Folge. COPD, umgangssprachlich "Raucherlunge", die zur ständigen Atemnot führt, ist Folge des Rauchens. Weniger bekannt ist, dass Raucher oft unter Potenzstörungen leiden. Jede Zigarette verkürzt das Leben im Durchschnitt um ca. 20 Minuten. Warum ist es so schwer mit dem Rauchen aufzuhören?
Nichtrauchen hat viele Vorteile, …


Zahnputzmuffeln droht Impotenz
Osterholz-Scharmbeck, den 28.07.2014: Impotenz kann viele Gründe haben. Das jedoch eine Zahnfleischentzündungen hinter Potenzstörungen stecken kann, vermuten jedoch die wenigsten. Genau dieses belegt allerdings eine türkische Studie.
An die Zahnbürste, Männer!
Für ihre Studie rekrutierte das Forscherteam um Faith Oguz 80 Männer zwischen 30 und 40 Jahren, …

Vom Raucher zum fitten Nichtraucher - Der VDF e.V. sorgt für Bewegung
… Muskulatur des Herzens und verschlechtert ihre Versorgung mit Sauerstoff. Damit stellt - neben ungesunder Ernährung und mangelnder Bewegung - vor allem das Rauchen eine vermeidbare Ursache für Herz-Kreislauferkrankungen dar. Dem DKFZ zufolge haben Raucher zudem ein 65 Prozent höheres Risiko, einen Herzinfarkt zu erleiden.
„Ein Raucher, der sich dies bewusst …

Individuelle Raucherentwöhnung mittels Hypnose
… mit Prüfungssituationen auch die Tiefenhypnose zur Raucherentwöhnung. Die Behandlungen werden in individuellen, auf jeden einzelnen Klienten zugeschnittenen Einzelsitzungen durchgeführt.Ursache fürs Rauchen mittels Tiefenhypnose ermitteln und neue Glaubenssätze implementieren
Viele Menschen schaffen es nicht, durch Eigeninitiative mit dem Rauchen aufzuhören, …

Medizinischer Sauerstoff fördert die Gesundheit
… Blutdruckwerte
• Beschleunigung der Rehabilitation
• Regeneration bei Erschöpfung und Müdigkeit
• Verbesserung des Schlafes
• Verbesserung des Hautzustandes
• Vorbeugung von Potenzstörungen
• Heilung von Heuschnupfen und Asthma
• Verminderung der Gefährlichkeit von Alterskrankheiten
• Entgiftung von Umweltbelastungen durch Auto- und Industrieabgase …


Gesundheitsfolgen des Rauchens - Dr. Elmar Basse - Hypnose Hamburg
… der Extremitäten kann es zu dem auch umgangssprachlich gut bekannten “Raucherbein” kommen.
Zu beachten ist aber auch, dass es infolge des Rauchens bei Männern zu Potenzstörungen kommen kann. Des Weiteren drohen Erkrankungen des Kiefers und des Zahnfleischs (erhöhtes Risiko der Parodontose, einer Entzündung mit der Folge einer Zerstörung des Zahnhalteapparates).
Darüber …

Welt-Nichtrauchertag: Rheumapatienten profitieren von Zigarettenverzicht
… milden und kontrollierbaren Krankheitsverlauf“, sagt Professor Ulf Müller-Ladner, Leiter der Abteilung Rheumatologie und klinische Immunologie an der Kerckhoff-Klinik Bad Nauheim. Ursache sei, dass Rauchen das Immungeschehen beeinflusse. Bei entzündlichem Rheuma bildet das Immunsystem Antikörper, die eine Zerstörung von körpereigenem Knorpelgewebe auslösen …
Sie lesen gerade: Potenzstörungen: Ursache kann das Rauchen sein